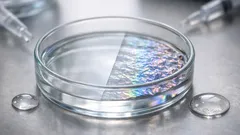
Pele sintética inspirada em polvos muda de textura e cor em segundos com água e álcool

Artigos sugeridos

Alimentação Saudável
Galinha da Páscoa no forno, bem dourada — com trigo sarraceno e molho do assado

Curiosidades & Lazer
Neurociência em 2025: 5 descobertas que mudam o que sabemos sobre memória, beleza e orientação

Curiosidades & Lazer
Gaia ajudou a medir a massa de um planeta errante a 10 mil anos-luz

Curiosidades & Lazer
Em Marte, os relógios adiantam: o que a relatividade muda na navegação interplanetária

Curiosidades & Lazer
Microrrobôs menores do que um grão de sal já se movem e “pensam” sem fios

Notícias & Atualidades
Robôs humanóides já trabalham à chuva: o que o IP66 muda no mundo real

Curiosidades & Lazer
Microrrobôs menores do que um grão de sal já se movem e calculam com luz de LED

Crescimento Pessoal
A luz da manhã é o truque simples que aumenta a energia e melhora o sono

Notícias & Atualidades
Microrrobô do tamanho de um inseto faz cambalhotas no ar e voa quase como um zangão

Curiosidades & Lazer
O que o James Webb descobriu sobre as atmosferas dos planetas de TRAPPIST-1

Bem-Estar e Saúde Natural
Depressão resistente ao tratamento: o que a inflamação pode estar a revelar

Alimentação Saudável
Galinha da Páscoa no forno, bem dourada — com trigo sarraceno e molho do assado
Curiosidades & Lazer
Pele sintética inspirada em polvos muda de textura e cor em segundos com água e álcool

Alimentação Saudável
Arroz de camarão no forno com topo gratinado — cremoso por dentro e dourado por cima

Curiosidades & Lazer
Porta USB do carro: para que serve mesmo e como tirar mais proveito

Alimentação Saudável
Bolo de Páscoa alto e fofo, recheado com creme de cacau e decoração festiva

Alimentação Saudável
Comentários